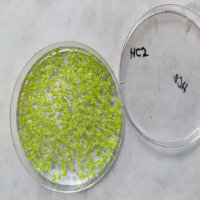
Wasserlinsen

|
|
|
Wie Pflanzenanbau auf
dem Mars funktionieren könnte
Wie versorgt man Astronautinnen und Astronauten während einer
Marsmission mit frischen Lebensmitteln? Eine Möglichkeit wäre der Anbau
von Pflanzen vor Ort - am besten mithilfe der lokal vorhandenen
Ressourcen. Einem Forschungsteam aus Bremen ist genau dies gelungen: Sie
stellten ein Düngemittel aus Marsressourcen her und nutzten es zum Anbau
von Wasserlinsen. [mehr]
|
Aus für
Gravitationswellendetektor GEO600 zum Jahresende
Der Gravitationswellen-Detektor GEO600 südlich von Hannover stellt zum
Ende des Jahres 2026 den Betrieb ein. Mit der Emeritierung des
Max-Planck-Direktors Karsten Danzmann am 31. März 2026 endet die
Förderung des GEO600-Projekts zum Jahresende. GEO600 hat für die
Gravitationswellenforschung wertvolle Beiträge geliefert. Im Sommer soll
noch einmal ein Tag der offenen Tür stattfinden.
[mehr]
|
|
Durch
Strömungsinstabilitäten zu richtigen Planeten
Wie fügt sich feiner Staub zu Bausteinen zusammen, aus denen
schließlich ganze Planeten wie unsere Erde entstehen? Ein Forschungsteam
hat bei Parabelflügen in der Schwerelosigkeit den ersten experimentellen
Nachweis erbracht, dass ein wichtiger physikalischer Prozess auch unter
Bedingungen auftritt, wie sie in Regionen herrschen, in denen Planeten
entstehen. [mehr]
|
|
| |
 |
Jahresrückblick
2025
Unser traditioneller Rückblick auf die Ereignisse aus Astronomie und
Raumfahrt im gerade zu Ende gegangenen Jahr. |
|
 |
Startrampe
Nächster Raketenstart: 24. Januar 2019, Satish Dhawan Space Center, Indien, PSLV, Microsat-R & Kalamsat |
| |
 |
Sternhimmel im
MärzVenus entwickelt sich zum hellen
Abendstern, sonst ist nur noch Jupiter präsent - zusammen mit den Sternen des Frühlings. |
|
Acht Experimente von
Studierenden gestartet
REXUS ist das Forschungsprogramm für Studierende der
Deutschen Raumfahrtagentur im DLR und der schwedischen Raumfahrtagentur SNSA.
Während der Projektzeit durchlaufen die Studierenden den gesamten Zyklus eines
echten Raumfahrtprojekts. In der vergangenen Woche sind wieder acht Experimente
an Bord von REXUS 35 und 36 gestartet. [mehr]
|
|
Strahlenbelastung im
All auf der Erde simuliert
Kosmische Strahlung ist eine der größten Herausforderungen für die
Raumfahrt und stellt ein erhebliches Risiko für Menschen und Materialien
dar. Einem internationalen Forschungsteam ist es an den Beschleunigeranlagen
von GSI/FAIR in Darmstadt gelungen, erstmals auf europäischem Boden einen
Simulator für galaktische kosmische Strahlung bereitzustellen. [mehr]
|
Langsamere Expansion
in unserer kosmischen Nachbarschaft
Ein internationales Forschungsteam hat die Expansion des
Universums in unserer unmittelbaren kosmischen Nachbarschaft mit einer
neuartigen Methode gemessen. Die Ergebnisse deuten darauf hin, dass sich das
lokale Universum langsamer ausdehnt als bisher angenommen. Außerdem dürfte
weniger Dunkle Materie erforderlich sein, um die Dynamik der Galaxien zu
erklären.
[mehr]
|
|
Standardmodell auf
über zwölf Nachkommastellen genau bestätigt
Ein Forschungsteam hat einen
der bislang genauesten Tests des Standardmodells der Teilchenphysik
durchgeführt. Mithilfe hochauflösender Wasserstoffspektroskopie bestätigten sie
die theoretischen Vorhersagen bis auf über zwölf Nachkommastellen. Die Messung
lieferte zudem einen präzisen Wert für den Protonenradius und löst das seit
Jahren diskutierte "Protonenradius-Rätsel".
[mehr]
|
|
MSL Missionslog
Verfolgen Sie den Verlauf der Mission des Marsrovers Curiosity in unserem
regelmäßig aktualisierten Missionslog. |
| |
 |
Forum
Was bringt eine bemannte Marsmission, sollen wir wieder zum Mond? Diskutieren Sie mit anderen Lesern im Forum! |
|
Feuerkugel über
Deutschland am Sonntagabend
Der Meteoroid, der am frühen Sonntagabend als helle
Feuerkugel in der Erdatmosphäre verglühte, dürfte einen Durchmesser von einigen
Metern gehabt haben. Das zeigen erste Analysen von Experten der europäischen
Weltraumorganisation ESA. Karlsruher Forschenden gelang es mithilfe
seismischer Daten eine genaue Bahn zu berechnen.
[mehr]
|
|
Ein großes
Wasserstoffreservoir im Erdkern?
Der Erdkern könnte das größte Wasserstoffreservoir des Planeten sein -
größer als Ozeane, Mantel und Atmosphäre zusammen. Das ist das Ergebnis
jetzt vorgestellter Laborexperimente unter extremen Druck. Die Resultate
sind nicht nur für die Modellierung von Prozessen im Erdinneren
interessant, sondern haben auch Folgen für Theorien zur Erdentstehung.
[mehr]
|
Verborgene Strukturen im jungen Universum
Mithilfe von Daten des Hobby-Eberly-Teleskops wurde nun die
bislang detaillierteste 3D-Karte der Lyman-Alpha-Emission erstellt, die
von Wasserstoff im frühen Universum ausgestrahlt wird. Auf diese Weise
können lichtschwache Galaxien und Gas identifiziert werden, die zuvor
schwer zu beobachten waren. Insgesamt wertete das Team ein halbes
Petabyte an Daten aus.
[mehr]
|
|
Blick auf den kosmischen Mittag mit BlueMUSE
Das Very Large Telescope der europäischen Südsternwarte
ESO soll einen neuen leistungsfähigen Spektrographen erhalten: Ab 2034
soll BlueMUSE mit einem großen Sichtfeld, einer hohen spektralen
Auflösung und einer außergewöhnlichen Effizienz im blauen
Wellenlängenbereich einzigartige Beobachtungen ermöglichen - insbesondere
in der Zeit des kosmischen Mittag.
[mehr]
|
Frühlingsbeginn am Himmel mit Venus und Jupiter
Der März bringt uns den Frühling, der offiziell am 20. März beginnt.
Entsprechend erobern sich die Frühlingssternbilder allmählich ihren Platz
am Abendhimmel. Die Venus entwickelt sich zum hellen Abendstern und der
helle Jupiter begleitet uns fast durch die gesamte Nacht, nur vom
Morgenhimmel zieht er sich zurück. Ansonsten machen sich die Planeten
aber rar. [mehr]
|
|
Vier
Planeten am Abend für das bloße Auge
Planetenfreunde kommen im Februar auf ihre Kosten: Mit Merkur,
Saturn und Venus sind drei Planeten am westlichen Abendhimmel zu sehen.
Hinzu gesellt sich noch der helle Gasriese Jupiter im Südosten. Außerdem
laden die Konstellationen des Winters zu einer Entdeckungsreise ein. Mit
dem Sternbild Löwen macht sich im Osten schon ein Frühlingsbote
bemerkbar. [mehr]
|
|
|
|